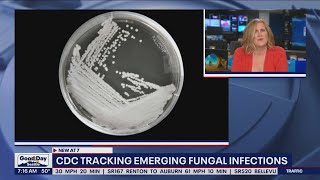

CDC tracking emerging fungal infections | FOX 13 Seattle video
Online izle ve mp4 mp3 formatlarinda yukle
Videonun muddeti: 3:39
CDC tracking emerging fungal infections | FOX 13 Seattle videosu mp4 ve mp3 yuklemek ucun hazirdir
Diqqet! Siz Mp4 yukle ve ya Mp3 yukle duymesine basdiqdan sonra eger sistem sizi reklam sehifesine atarsa o zaman derhal geri qayidib emeliyyati tekrar edin ve faylin yuklemek ucun hazir olmasini gozleyin
Videodan Mp4 Yukle
Videodan Mp3 Yukle-1
Videodan Mp3 Yukle-2
Oxshar Axtarishlar
CDC tracking emerging fungal infections | FOX 13 Seattle
Candida Auris Fungus: Infections Spreading at ‘Alarming Rate' #shorts
#Health #hazard: #CDC says #deadly #fungus is #spreading across #US #healthcare facilities
CDC reports increase in norovirus cases | FOX 13 Seattle
CDC concerned about rapid spread of drug-resistant fungal infections
CDC warns dangerous fungus infection poses threat nationwide
CDC: Rise in fungal infections
CDC Warns Of 'Alarming' Rise Of Potentially Deadly Fungal Threat In Hospitals
Health Watch: CDC warns about fungal infections from surgical procedures in Mexico
Video Mp4 Mp3Azwap.Biz
Azwap.Biz 2021-2023